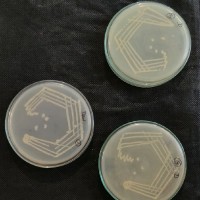
Sneha P

Company Details
- Employees
- 17
- Founded
- 2010
- Address
- # 461/ 3 Amman Nagar (Near Chandran Steels) Lt By Pass Road Eachanari Post, Coimbatore,tamil Nadu 641062,india
- Industry
- Biotechnology
- Website
- http://www.cbnrindia.com/
- Keywords
- Coimbatore.
- HQ
- Coimbatore, Tamil Nadu
- Competitors
- Biozone Research Technologies Pvt. Ltd, CSIR - Central Leather Research Institute, Aura Biotechnologies Private Limited (AURA BIOTECH), GeneX India Bioscience Pvt Ltd, Centre for Nano Science and Engineering (CeNSE), Institute for Stem Cell Science and Regenerative Medicine (BRIC-inStem), Viyen Biotech, Centre For Bioscience And Nanoscience Research, Centre for Stem Cell and Cancer Genomics, AM Institute of BioScience, ICAR- Indian Council of Agricultural Research.